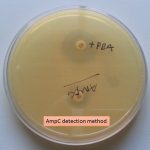
Ampc detection method

Collection Group: Clinical Bacteriology
AmpC: Introduction, Clinical significance and Detection Method for Gram Negative Bacteria
Introduction and Clinical Significance of AmpC AmpC β-lactamases are enzymes...
Introduction and Clinical Significance of AmpC AmpC β-lactamases are enzymes...
Ziehl -Neelsen Stain of Sputum: Introduction, Principle, Procedure and Result Interpretation
 Ziehl -Neelsen Stain of Sputum Ziehl -Neelsen stain of sputum...
Ziehl -Neelsen Stain of Sputum Ziehl -Neelsen stain of sputum...
AFB Stain of Sputum Showing AFB Positive: Introduction, Principle, Result Interpretation
 AFB Stain of Sputum Showing AFB Positive AFB stain of...
AFB Stain of Sputum Showing AFB Positive AFB stain of...
